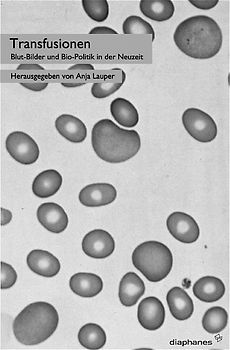
Transfusionen

Nomaden in unserer Welt
Sehr gut

Historische Umbrüche im deutschen Drama des 20. Jahrhunderts
Nur als Neuware

Dissertations and Theses from Start to Finish
Nur als Neuware

Erinnern und Gedenken
Sehr gut

Secrets of Teaching ESL Grammar: A Fun, Easy-to-Understand, Fast-Paced, Intensive, Step-by-Step Manual on How to Teach ESL Grammar
Nur als Neuware

Von Jesus kein Lebenszeichen!: Zur Realgeschichte von Christentum und Islam von den Anfängen bis zur Gegenwart
Sehr gut

Besser schreiben in jeder Situation: An Beispielen lernen
Sehr gut

The Star Wars Rings: The Hidden Structure Behind the Star Wars Story
Sehr gut

Die Sehnsucht nach dem Gesamtkunstwerk
Gut

Europas Sprachen und Kulturen im Wandel der Zeit
Sehr gut

CHINESISCH DEUTSCH BILDERWÖRTERBUCH: Kinderbuch zum Chinesichlernen, Mädchen und Jungen, Anfänge, farbiges Aktivitätsbuch, erste Wörter auf chinesisch
Exzellent

Psychoanalyse, Politik und Dekonstruktion
Nur als Neuware

Compelling American Conversations: Questions & Quotations for Intermediate American English Language Learners (Compelling Conversations, Band 3)
Sehr gut
Lieber Geld verdienen als ausgeben?
Verkauf Elektronik und Medien ganz einfach an uns
Versand immer kostenlos und versichert 100 % Löschung deiner Daten Erfahrung und Sicherheit seit 2004
Der Streichpreis bezieht sich auf die unverbindliche Preisempfehlung des Herstellers, den aktuellen durchschnittlichen Neupreis des Produktes bei idealo Deutschland, oder bei Büchern auf den festgelegten Preis für Neuware.